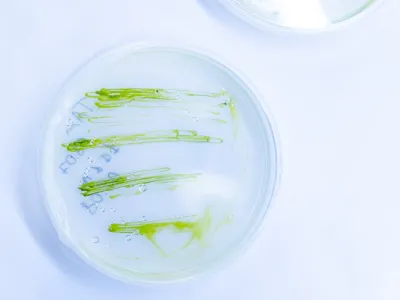
Испытание водорослей и цианобактерий на задержку роста

Лабораторые испытания
Выберите направление исследований

Вымывание из почвенных колонок
Подробнее →
Определение репродуктивной способности коллембол
Подробнее →
Хищные клещи: репродуктивный тест в почве
Подробнее →
Тест на репродуктивность дождевых червей
Подробнее →
Определение острой токсичности для дождевых червей
Подробнее →
Испытание ряски на угнетение роста
Подробнее →
Определение острой токсичности для рыб
Подробнее →
Определение острой токсичности для дафний
Подробнее →